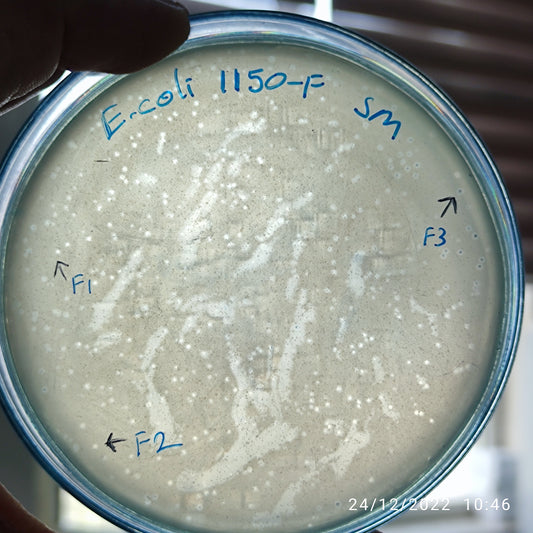
Escherichia coli bacteriophage 101150F
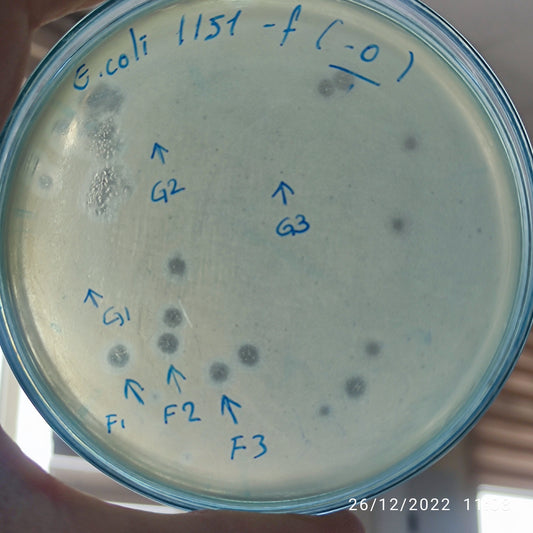
Escherichia coli bacteriophage 101151F
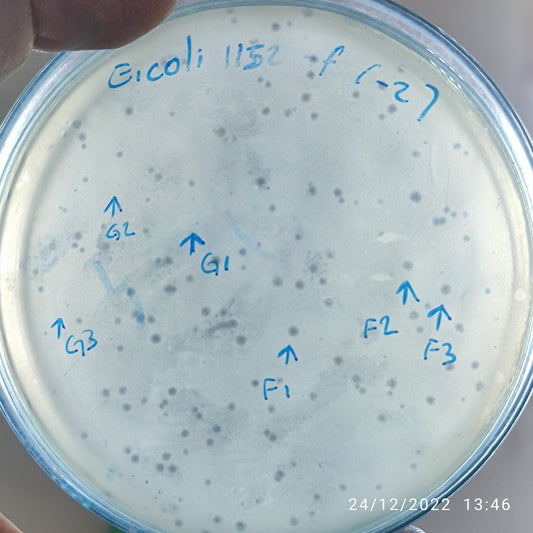
Escherichia coli bacteriophage 101152F
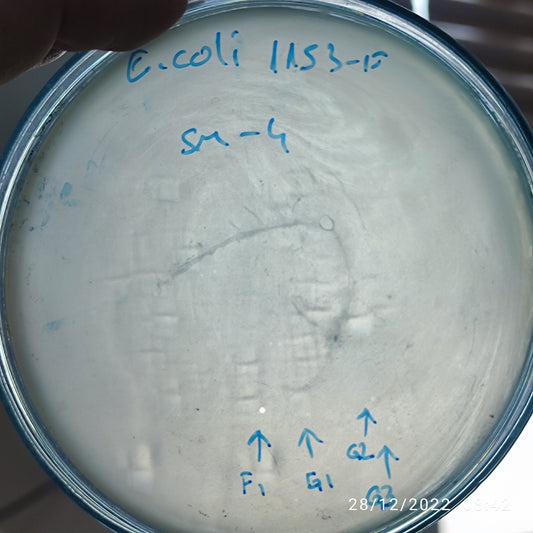
Escherichia coli bacteriophage 101153F
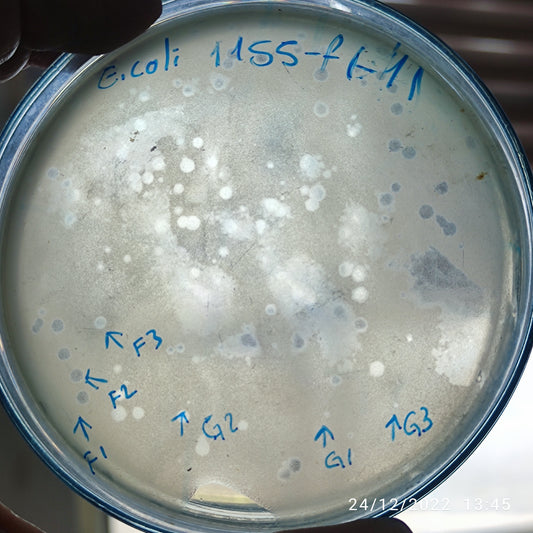
Escherichia coli bacteriophage 101155G
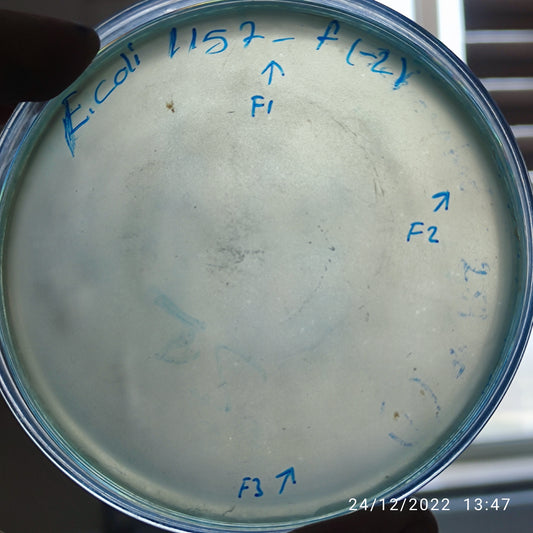
Escherichia coli bacteriophage 101157F
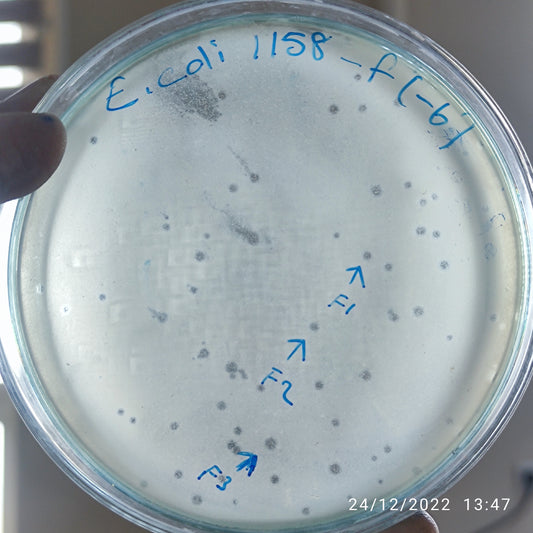
Escherichia coli bacteriophage 101158F
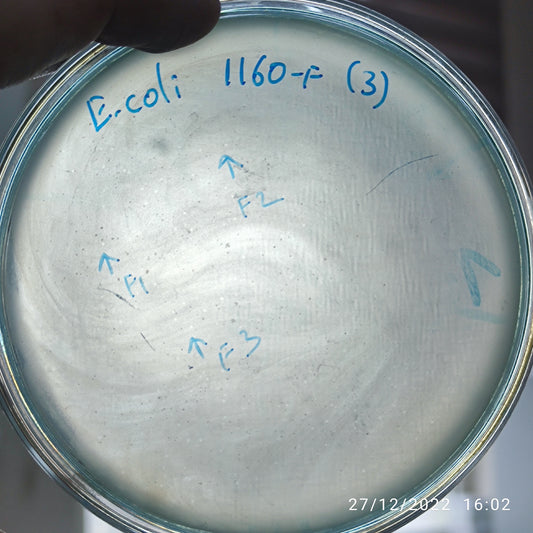
Escherichia coli bacteriophage 101160F
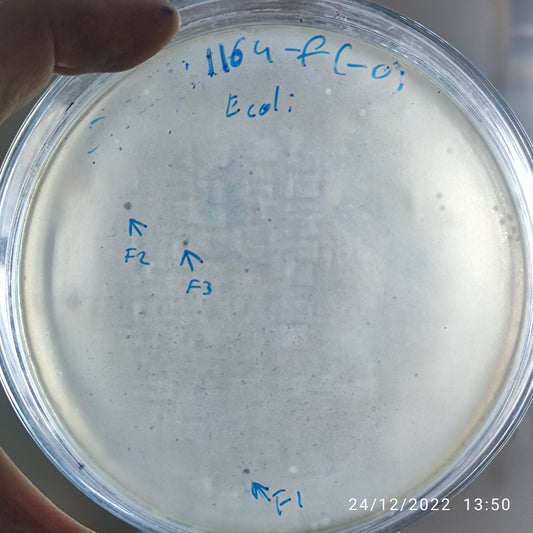
Escherichia coli bacteriophage 101164F

-
Escherichia coli bacteriophage 101150F
Regular price $500.00 USDRegular priceUnit price per -
Escherichia coli bacteriophage 101151F
Regular price $500.00 USDRegular priceUnit price per -
Escherichia coli bacteriophage 101151G
Regular price $500.00 USDRegular priceUnit price per -
Escherichia coli bacteriophage 101152F
Regular price $500.00 USDRegular priceUnit price per -
Escherichia coli bacteriophage 101152G
Regular price $500.00 USDRegular priceUnit price per -
Escherichia coli bacteriophage 101153F
Regular price $500.00 USDRegular priceUnit price per -
Escherichia coli bacteriophage 101153G
Regular price $500.00 USDRegular priceUnit price per -
Escherichia coli bacteriophage 101154F
Regular price $500.00 USDRegular priceUnit price per -
Escherichia coli bacteriophage 101155F
Regular price $500.00 USDRegular priceUnit price per -
Escherichia coli bacteriophage 101155G
Regular price $500.00 USDRegular priceUnit price per -
Escherichia coli bacteriophage 101156F
Regular price $500.00 USDRegular priceUnit price per -
Escherichia coli bacteriophage 101157F
Regular price $500.00 USDRegular priceUnit price per -
Escherichia coli bacteriophage 101158F
Regular price $500.00 USDRegular priceUnit price per -
Escherichia coli bacteriophage 101160F
Regular price $500.00 USDRegular priceUnit price per -
Escherichia coli bacteriophage 101162F
Regular price $500.00 USDRegular priceUnit price per -
Escherichia coli bacteriophage 101164F
Regular price $500.00 USDRegular priceUnit price per